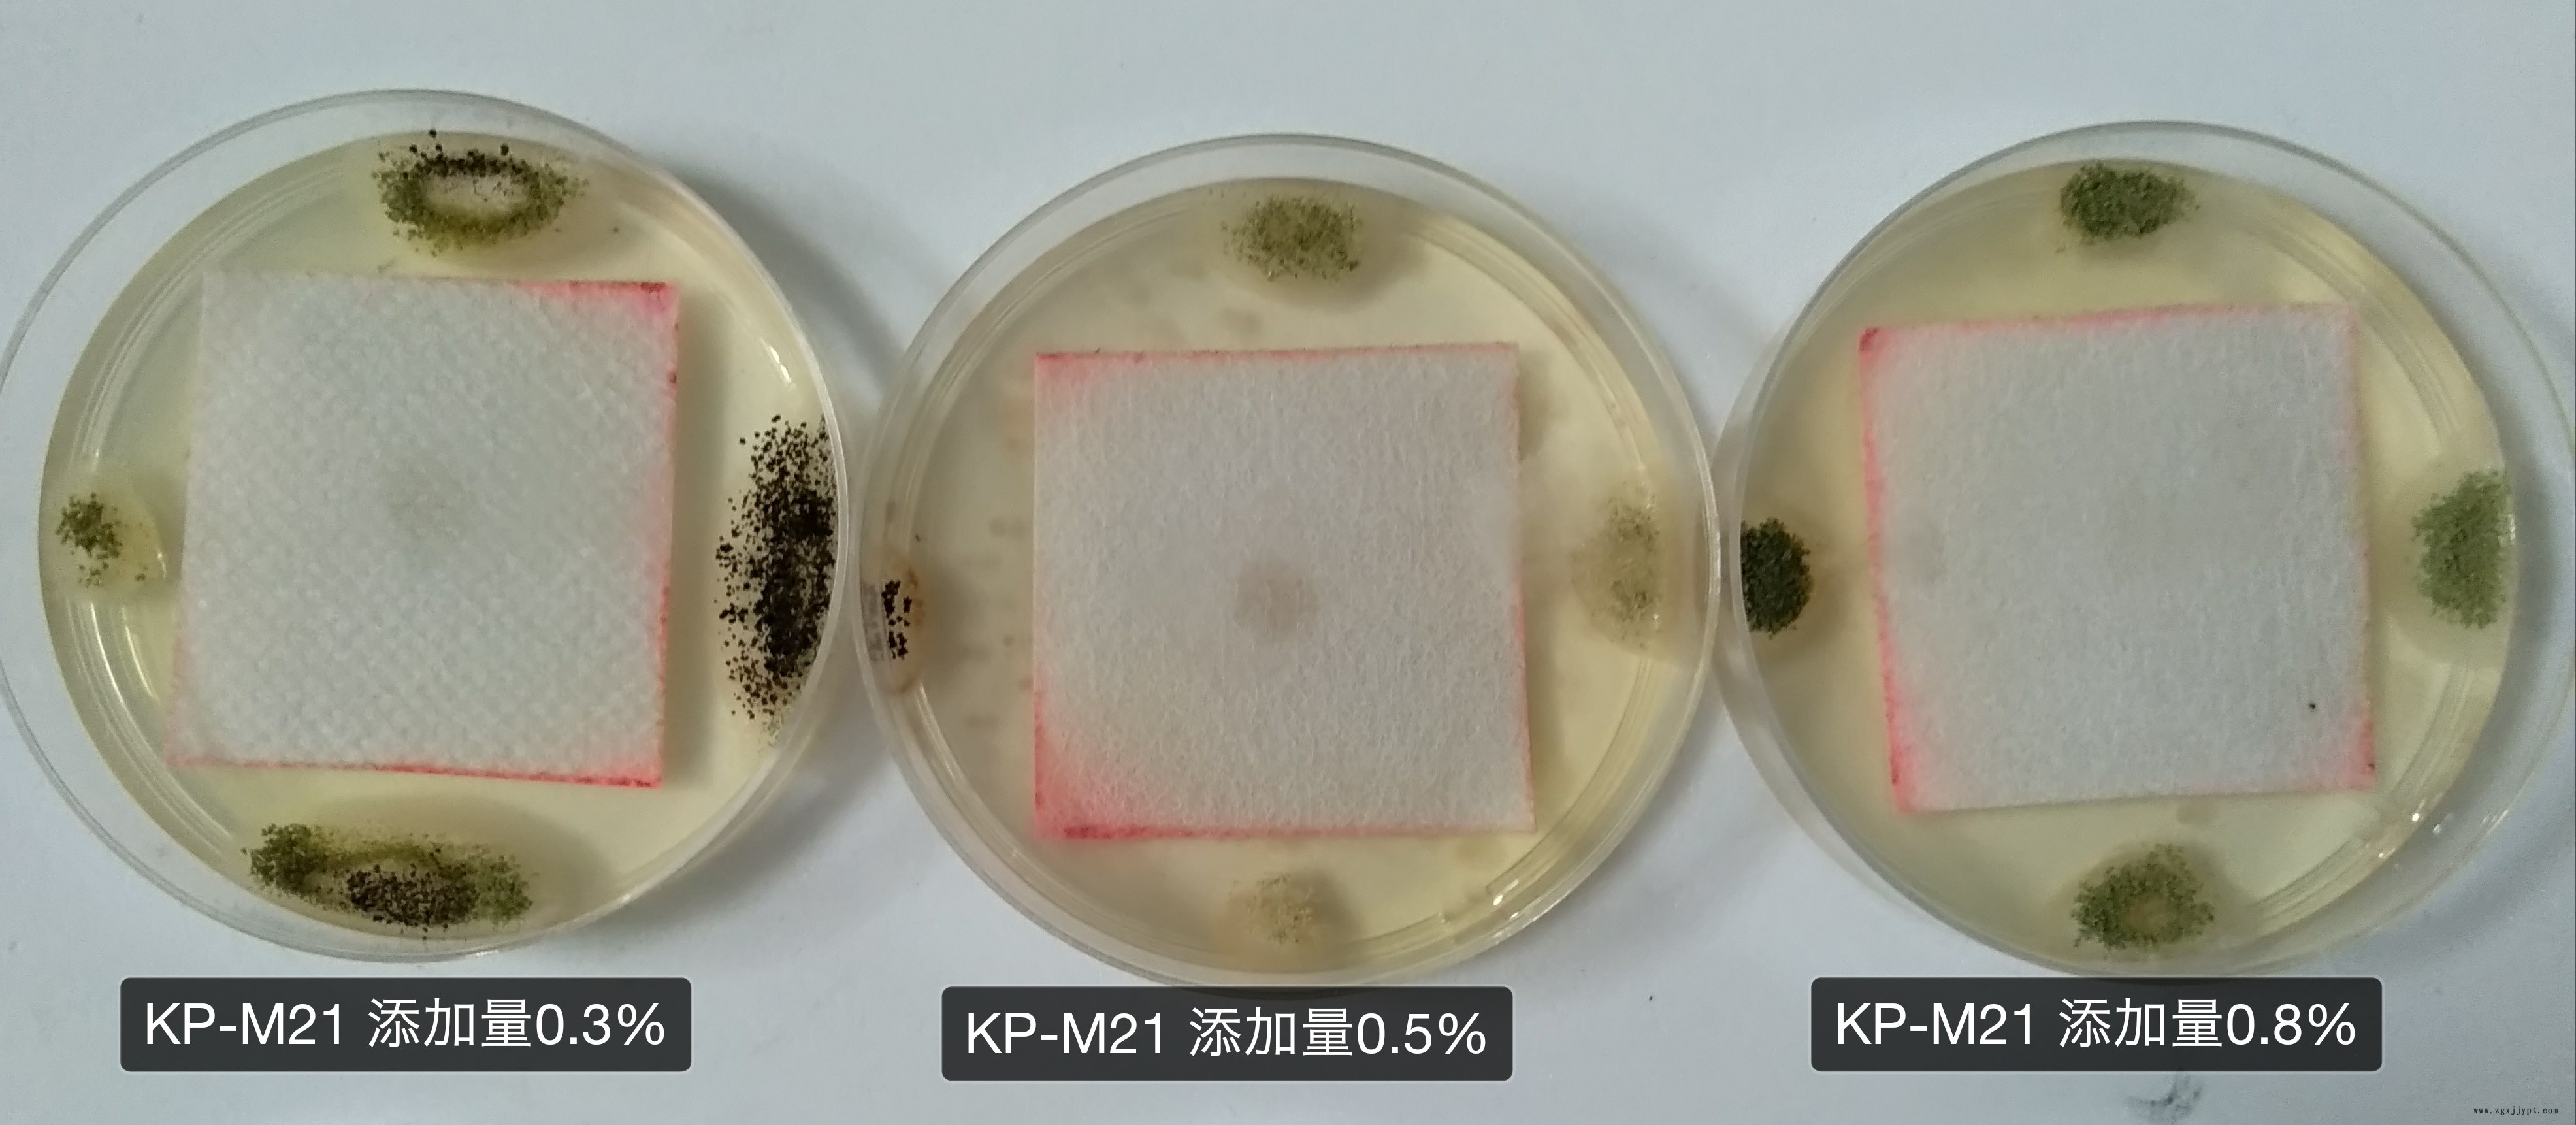

| 品牌 : | 國產 | 型號 : | KP-M20 |
| 外觀 : | 防霉液 | 產品規格 : | 25kg |
| 主要用途 : | 皮革用 | 尺寸 : | 透明無色液體 |
| 有效物質含量 : | 98 | 適用范圍 : | 用于藍濕革防酶加工、鉻鞣、加脂工藝使用 |
| 特色服務 : | 免費拿樣品測試 |
?
防酶劑(添加型)KP-M20
添加型防霉劑KP-M20 透明無色環保持久防霉抗菌劑
防酶劑(添加型)KP-M20產品概述
? ? 科普茵自主研發的防酶劑(添加型) KP-M20采用全水性配方和全新的微乳化體系,味道輕微且趨近于無,5種防酶劑,3種促進劑,2種滲透劑分配而成,具有極高的安全性,低毒,不易燃易爆,防酶效果 ,不產生抗藥性的特點;
? ? 適用于處理 大多數皮革制作時使用。對黑曲酶、黃曲酶、綠色木酶、球毛殼酶、白色 等數百種致病菌都有優異的殺滅作用,對皮膚刺激性小。

防酶劑(添加型)KP-M20產品特征
1、抗菌性能優異、殺菌廣譜、尤其對曲酶、青酶等有 ;
2、根據特殊需求可以使用純水性配方,使用成本,使用和運輸安全;
3、產品粒度小,分散均勻;
4、不含重金屬,對人體刺激性小,產品安全環保;
5、耐溫性良好,且適用的pH范圍廣泛,2-10均可使用;
6、不改變基體的顏色和其它物理化學性質。
項目 | 指標 |
外觀 | 乳白色懸浮液體 |
密度 | 1.141.20g/ml |
耐熱性 | 小于150 |
Ph(25) | 5.08.0 |
有效含量 | 大于40 |
防酶劑(添加型)KP-M20應用范圍
? ? ? ??適用于藍濕革防酶加工、鉻鞣、加脂工藝使用,水性白乳膠,水洗樹脂防酶抗菌添加處理。
防酶劑(添加型)KP-M20使用說明
? ? ? ??在鉻鞣過程中使用:建議在鉻粉加入 20-30 分鐘后加入 0.10.3 KP-M20,用適量的水稀釋后立即加入。(另外建議分兩部分加入:浸酸段和鉻鞣段加入)
? ? ?在液體成膜型產品中添加使用:建議加入助劑重量的 0.51 KP-M20,攪拌均勻后正常工藝制作。?
? ? ?備注:本品對易過敏者會造成眼睛和皮膚有刺激,使用操作時必須戴手套、眼罩和口罩。避免接觸皮膚、眼睛和粘膜。一旦與皮膚和眼睛接觸立即用大量清水及肥皂清洗并及時就醫。

